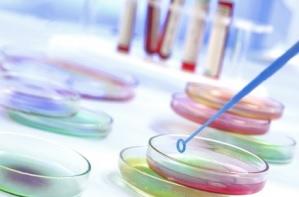

Actualités
Mode d'affichage :
-
CRISE CARDIAQUE: Risque, survie et récupération, tout est dans la forme physique!
Actualité publiée il y a 10 années 2 moisPARKINSON: Plus de 25 ans avant, les chutes annoncent déjà la maladie
Actualité publiée il y a 10 années 2 mois
-
HORLOGE BIOLOGIQUE: Et si on écoutait un peu nos gènes ?
Actualité publiée il y a 10 années 2 moisDIABÈTE: Une heure passée assis de trop, c'est 20% de risque en plus
Actualité publiée il y a 10 années 2 mois
-
CHIRURGIE et PLAIES VASCULAIRES: Un matériau biodégradable pour une juste cicatrisation
Actualité publiée il y a 10 années 2 moisALLAITEMENT: Le microbiome du lait maternel détermine le microbiote de l'enfant
Actualité publiée il y a 10 années 2 mois
-
OBÉSITÉ INFANTILE: Un petit déjeuner protéiné modère l'apport calorique de la journée
Actualité publiée il y a 10 années 2 moisTABAGISME PASSIF: Il prend la tête et donne du ventre aux enfants
Actualité publiée il y a 10 années 2 mois
-
CERVEAU: Ils décodent ses signaux à la vitesse de la perception
Actualité publiée il y a 10 années 2 moisCANCER: Le mito-amorçage pour détecter les anticancéreux efficaces
Actualité publiée il y a 10 années 2 mois
-
OBÉSITÉ: Une cuisine mal rangée incite à grignoter
Actualité publiée il y a 10 années 2 moisPLAIES INFECTÉES: L'electro-stimulation efficace contre l'infection
Actualité publiée il y a 10 années 2 moisLutter contre les bactéries résistantes aux antibiotiques, comme le staphylocoque doré résistant à la Méthicilline (SARM) et contre les biofilms est un défi de ...
-
CANCER en France: Des données de survie hétérogènes mais encourageantes
Actualité publiée il y a 10 années 2 moisCYBERTHÉRAPIE: Vaincre ses peurs grâce à la réalité virtuelle
Actualité publiée il y a 10 années 2 mois
-
SOINS de PANSEMENT: Les grands axes de progrès dans la cicatrisation des plaies
Actualité publiée il y a 10 années 2 moisCANCER du SEIN: Des indices épigénétiques déjà présents dans le tissu sain
Actualité publiée il y a 10 années 2 mois
-
AUTISME: De nouvelles preuves sur le lien avec l'obésité et le diabète chez la mère
Actualité publiée il y a 10 années 2 moisÉDITION du GÉNOME: Autorisation à des fins de recherche sur l'embryon
Actualité publiée il y a 10 années 2 moisMieux comprendre le rôle des gènes clés au cours des tout premiers jours du développement des cellules qui forment ensuite le placenta, et du développement de ...
-
CANCER du SEIN: Une alimentation riche en fibres dès l'adolescence pour réduire le risque
Actualité publiée il y a 10 années 2 moisMaladies de l'INTESTIN: Les neurones prêtent main forte aux cellules immunitaires
Actualité publiée il y a 10 années 2 mois
-
SCLÉROSE latérale amyotrophique : Un traitement stoppe sa progression chez la souris
Actualité publiée il y a 10 années 2 moisUn PANSEMENT STEM-GEL: Des cellules souches encapsulées dans des billes d'alginate
Actualité publiée il y a 10 années 2 moisLes progrès technologiques se succèdent en matière de dispositifs de pansement. Une étude toute récente montrait les bénéfices de la combinaison alginates ( ...
-
RECONSTRUCTION MAMMAIRE: L'injection de graisse n'augmente pas le risque de cancer
Actualité publiée il y a 10 années 2 moisOBÉSITÉ: L'interrupteur épigénétique qui rend l'un maigre et l'autre obèse
Actualité publiée il y a 10 années 2 mois
-
AUTISME: Des différences cérébrales subtiles identifiées chez les hommes atteints
Actualité publiée il y a 10 années 2 moisPSYCHO: Le bien-vivre son âge a un effet direct sur la santé
Actualité publiée il y a 10 années 2 mois
-
OBÉSITÉ: Les flavonoïdes des fruits qui favorisent la perte de poids
Actualité publiée il y a 10 années 2 moisDOULEUR CHRONIQUE: Elle dévaste le cerveau et le système immunitaire
Actualité publiée il y a 10 années 2 mois
-
AUTISME: De l'effet possible des infections virales durant la grossesse
Actualité publiée il y a 10 années 2 moisÉDITION du GÉNOME: Elle inverse une forme de cécité génétique
Actualité publiée il y a 10 années 2 mois
-
ALLAITEMENT MATERNEL: Un engagement responsable tout autant que sanitaire
Actualité publiée il y a 10 années 2 moisCICATRISATION: Des algues et des crustacés pour des pansements encore plus absorbants
Actualité publiée il y a 10 années 2 mois
-
PARACÉTAMOL: Pris pendant la grossesse il peut réduire la fertilité des filles
Actualité publiée il y a 10 années 2 moisPARKINSON: Une étape décisive dans la compréhension de la maladie
Actualité publiée il y a 10 années 2 mois
Pages